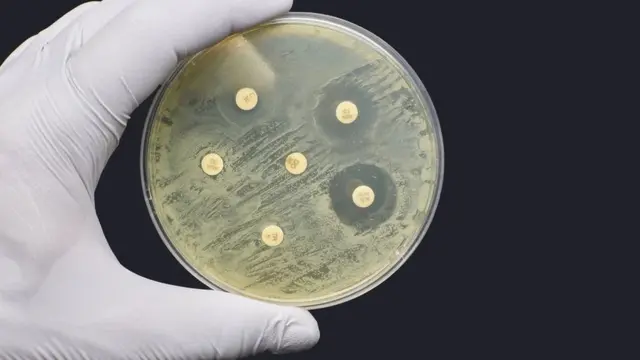
البكتيريا

الأمراض المقاومة للمضادات الحيوية "تقتل الملايين" حول العالم

صدر الصورة، Getty Images
- Author, فيليبا روكسبي
- Role, محررة الصحة
كشف تقرير عالمي وفاة أكثر من 1.2 مليون شخص عبر العالم بسبب عدوى بكتيرية مقاومة للمضادات الحيوية.
وهذا عدد أكبر من مجموع الوفيات التي سببها الملاريا أو الأيدز.
وأفاد التقرير بأن الدول الفقيرة هي الأكثر عرضة للظاهرة، ولكن مقاومة المضادات الميكروبية خطر يهدد جميع الناس في كل العالم.
ويدعو الخبراء إلى الاستثمار في عقاقير جديدة، واستعمال الأدوية الموجودة بعقلانية أكثر، كي تظل صالحة في مواجهة البكتيريا.
فالاستعمال المفرط للمضادات الحيوية لعلاج أنواع بسيطة من العدوى في السنوات الأخيرة، قلل من فعاليتها أمام أنواع العدوى الخطيرة.
وهذا ما جعل الناس اليوم يموتون من عدوى اعتيادية كانت من قبل قابلة للعلاج، لأن البكتيريا المسببة لها أصبحت الآن قادرة على مقاومة العقاقير.
وحذر المسؤولون عن الصحة في بريطانيا، في الفترة الأخيرة، من أن مقاومة المضادات البكتيرية "وباء خفي" يمكن أن يندلع بعد وباء فيروس كورونا، ما لم يلتزم وصف المضادات الحيوية بالعقلانية.
ظاهرة فتاكة
واعتمد التقرير، الذي نشر في مجلة لانست، على عدد الوفيات في 204 دول. وأشرف على الدراسة خبراء دوليون، بقيادة جامعة واشنطن، في الولايات المتحدة.
صدر الصورة، Getty Images
وأحصى الباحثون وفاة 5 ملايين شخص في 2019 بسبب أمراض مرتبطة بمقاومة المضادات الحيوية، فضلا عن وفاة 1.2 مليون شخص، بسبب مقاومة المضادات الحيوية مباشرة.
وفي العام نفسه، تشير الإحصائيات إلى أن الأيدز سبب وفاة 860 ألف شخص، في العالم، بينما بلغ عدد ضحايا وباء الملاريا 640 ألف شخص.
ووقعت أغلب وفيات الناتجة عن أمراض مقاومة للمضادات الحيوية بسبب عدوى في الجهاز التنفسي، مثل الالتهابات الرئوية، والتهابات مجرى الدم، التي قد تؤدي إلى تعفن الدم.
ويرى الباحثون، الذين اعتمدوا على سجلات المستشفيات ودراسات ومصادر أخرى، أن الأطفال الصغار أكثر عرضة للوفاة، إذ أن خمس الحالات هي بين البالغين من العمر أقل من 5 سنوات.
ويشير التقرير إلى نسب الوفيات بسبب مقاومة المضادات الحيوية كانت:
- الأعلى في دول جنوب الصحراء الأفريقية وجنوب آسيا بمعدل 24 وفاة بين كل 100 ألف؛
- الأدنى في الدول الأكثر دخلا بمعدل 13 بين كل 100 ألف.
وقال البروفيسور كريس موري، من معهد القياسات الصحية والتقييم في جامعة واشنطن، إن البيانات الجديدة كشفت درجة مقاومة الميكروبات عالميا، وأطلقت تنبيها صريحا إلى ضرورة اتخاذ إجراءات عاجلة "إذا أردنا أن نبقى متقدمين في السباق ضد مقاومة الميكروبات" للمضادات الحيوية.
ويرى خبراء آخرون أنه من الضروري تحسين مراقبة مستويات المقاومة في مختلف الدول والأقاليم.
وقال الدكتور رامانان لكسمينارايان، من مركز دراسات ديناميكية المرض والاقتصاد والسياسات في واشنطن دي سي، إنه ينبغي رفع قيمة الإنفاق العالمي على مقاومة المضادات الحيوية إلى مستوى الإنفاق على معالجة أمراض أخرى.
وأضاف أن "الإنفاق لابد أن يوجه إلى مكافحة العدوى أساسا، ثم التأكد من أن استعمال المضادات الحيوية يتم بطريقة سليمة، وبعدها توفير مضادات حيوية جديدة في السوق".
وتابع يقول إن "أغلب دول العالم واجهت صعوبة في الحصول على مضادات حيوية بأسعار معقولة وذات فعالية، وهذا أمر لابد أن يؤخذ مأخذ الجد من قبل الزعماء السياسيين والمسؤولين عن الصحة في كل مكان".






























